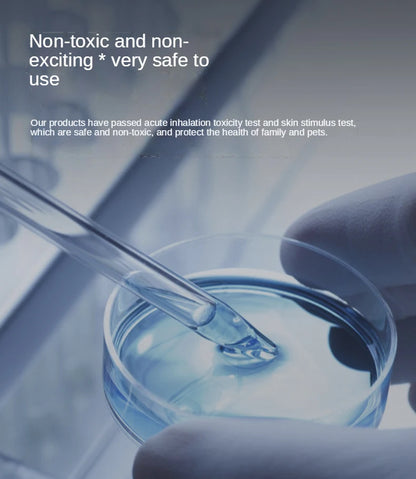
PETKIT N50 Odor Eliminator for Pura Max Self-Cleaning Cat Litter Box Original Toilet Odor Control Air Use 6 Mouths

1
/
of
19
PETKIT N50 Odor Eliminator for Pura Max Self-Cleaning Cat Litter Box Original Toilet Odor Control Air Use 6 Mouths
PETKIT N50 Odor Eliminator for Pura Max Self-Cleaning Cat Litter Box Original Toilet Odor Control Air Use 6 Mouths
Regular price
$61.90 CAD
Regular price
$61.90 CAD
Sale price
$61.90 CAD
Unit price
/
per
Couldn't load pickup availability
Share
SPECIFICATIONS
Brand Name: NoEnName_Null
Choice: yes
Hign-concerned Chemical: None
Item Type: Cat Cleaning Tools
Model Number: PETKIT N50
Origin: Mainland China
Set Type: Yes
semi_Choice: yes